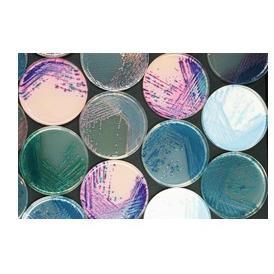
1000ml弧菌显色培养基(副溶血性)等显色培养基干粉系列

欧洲直邮德国拜耳Aspirin阿司匹林100mg预防血栓溶血肠溶片 98粒


德国拜耳Aspirin阿司匹林100mg预防心梗血栓溶血肠溶片98粒


【98粒大容量】德国拜耳Aspirin阿司匹林100mg预防血栓溶血肠溶片


欧洲直邮德国药房Stada心脑梗血栓溶血乙酰水杨酸100mg肠溶片100


欧洲直邮德国药房ratiopharm乙酰水杨酸100mg血栓溶血肠溶片100粒


欧洲直邮德国药房ratiopharm乙酰水杨酸100mg血栓溶血药片50粒


尿隐血试纸优利特家用检测肾结石尿液分析仪潜血非溶血尿道感染ZX

1000ml弧菌显色培养基(副溶血性)等显色培养基干粉系列


欧洲直邮德国药房ratiopharm乙酰水杨酸50mg血栓溶血药片100粒


欧洲直邮德国药房ratiopharm乙酰水杨酸100mg血栓溶血药片100粒


信谊维生素E软胶囊药用100mg*30片/盒手足抽搐溶血性贫血LM


维生素E软胶囊ve维e面部发育迟缓、溶血性贫血100mg*30粒/瓶


迈瑞溶血剂血细胞用溶血剂三分类溶血剂M-3CFL500ml/瓶全套试剂


BHA3000血球稀释液溶血剂关机质控


血细胞分析用溶血剂吉林紫宸维尔新达稀释液清洗液血球试剂溶血素


【单项】猫咪猫血型检测宠物基因检测溶血全血型筛查输血繁育配种


迈瑞五分类血细胞平替试剂BC5000等多种型号稀释液清洗液溶血剂


【98粒大容量】德国拜耳Aspirin阿司匹林100mg预防血栓溶血肠溶片


欧洲直邮德国药房ratiopharm乙酰水杨酸100mg血栓溶血肠溶片50粒


迈瑞五分类血细胞平替试剂BC5000等多种型号稀释液清洗液溶血剂


欧洲直邮德国药房赫素Hexal乙酰水杨酸100mg心脑梗血栓溶血药片50


欧洲直邮赫素Hexal乙酰水杨酸100mg心溶血药片50粒


欧洲直邮赫素Hexal乙酰水杨酸100mg心溶血药片50粒


德国拜耳Aspirin阿司匹林100mg预防血栓溶血肠溶片98粒


欧洲直邮德国药房赫素Hexal乙酰水杨酸100mg心脑血栓溶血药片100


欧洲直邮德国药房ratiopharm乙酰水杨酸100mg血栓溶血肠溶片100粒


紫宸血液检测仪试剂紫宸试剂稀释液溶血剂多酶清洗液探头保养液


浩江各型号血细胞分析仪血球仪通用C2E酶管道清洗液稀释液溶血剂


【血型卡】猫血型检测试纸英科诺维NEOVET DX繁育溶血A型B型AB型


预订 Les Sérums Hémolytiques: Injections de Sérum Hémolytique Dans Les Anémies 溶血血清:贫血时注射溶血血清: 978201


预订 Le Pouvoir hémolytique du sérum sanguin et la résistance globulaire, recherches chez l’enfant 儿童血清的溶血力


预订 Les Hémorragies Sous-Arachnoïdiennes Et Le Mécanisme de l’Hématolyse En Général 蛛网膜下腔出血和溶血机制: 97


血型相关胎儿新生儿溶血病


预订 Risk Assessment of Vibrio Parahaemolyticus in Seafood 海鲜中副溶血性弧菌风险评估。解释性的总结(fao111314): 978925


YY/T 0456.2-2003血细胞分析仪应用试剂 第2部分:溶血剂


YY/T 0456.2-2014血液分析仪用试剂 第2部分:溶血剂


预订 Autoimmune Hemolytic Anemias: A Practical Guide 自身免疫性溶血性贫血:实用指南: 9780443315206


血型相关胎儿新生儿溶血病 李翠莹 封志纯编 重点介绍了血型不合胎儿新生儿溶血病的临床表现 辅助检查及临床诊断等9787117371872


正版HY/T 151-2013海洋微藻中溶血毒素的检测 血细胞法


正版YY/T 0456.2-2014血液分析仪用试剂第2部分:溶血剂

